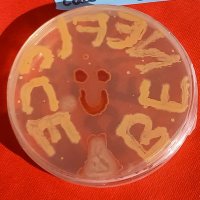

IPREM UMR5254
@umr5254
Institut des Sciences Analytiques et de Physico-Chimie pour l'Environnement et les Matériaux - Unité Mixte de Recherche @CNRS @universite_uppa @IMTMinesAles
ID: 1063065275749281793
https://iprem.univ-pau.fr/ 15-11-2018 13:44:47
202 Tweet
223 Followers
85 Following


Après plus de 18 ans d’existence, SPECTRATOM est maintenant devenu le rendez-vous incontournable des scientifiques et opérateurs francophones de la spectrométrie atomique. Congrès du 10 au 13 mai 2022 Coordinateur principal : Christophe PECHEYRAN IPREM UMR5254 spectratom2022.sciencesconf.org

1ère candidate à s’élancer, Élise Duret est doctorante en chimie Université de Pau et des Pays de l'Adour (UPPA) au sein de l’IPREM UMR5254 et nous parle de son travail pour des meubles en bois + durables et naturels ! #MT180



🔋 "Énergie : comment vont évoluer les batteries lithium-ion, très consommatrices de métaux en tension ?" 🔋 —- Découvrez l'article dans The Conversation France de 2 de nos chercheurs au sein de notre laboratoire IPREM UMR5254 à l'Université de Pau et des Pays de l'Adour (UPPA) ! —- ⚡️ theconversation.com/energie-commen…

If you are BPC today at the cocktail 🍹 time I will be pleased to introduce you to a piece of work made Le Mans Université in collaboration with IPREM UMR5254 IPREM on hyper-branched copolymers. So please feel free to come and see me #A-24 poster 😊

Université de Pau et des Pays de l'Adour (UPPA) IPREM UMR5254 La Rochelle Université UMR LIENSs Universitat de les Illes Balears - UIB Universidade Porto AMAYA - CENTA SATT Aquitaine UNIMA Mancomunidad de Municipios Sostenibles Proyecto Geoparque Valles de Cantabria Diputación de Huelva ParalabSA, Laboratoires des Pyrénées et des Landes

Université de Pau et des Pays de l'Adour (UPPA) IPREM UMR5254 La Rochelle Université UMR LIENSs Universitat de les Illes Balears - UIB Universidade Porto AMAYA - CENTA SATT Aquitaine UNIMA Mancomunidad de Municipios Sostenibles Proyecto Geoparque Valles de Cantabria Diputación de Huelva ParalabSA, Laboratoires des Pyrénées et des Landes


Journée de bilan de l'Equipex MARSS à l'IPREM IPREM UMR5254, lundi 18 juillet recherche.univ-pau.fr/fr/expertise/l…

Workshop IPREM UMR5254 ( E2S UPPA, CNRS Aquitaine) 16-17 Mars 2023. "Waste valorization, microbial communities, and circular economy: producing commodities and solving environmental problems"


Cécile Courrèges, chercheuse CNRS à l'IPREM, IPREM UMR5254 (CNRS Aquitaine, Université de Pau et des Pays de l'Adour (UPPA)) 2ème lauréate du concours photo : "habillage façade de la délégation CNRS Aquitaine". Son visuel "Extrême Surface" sera donc affiché dans la délégation pour une durée de deux ans.



Offre d'emploi: Post-Doctorat IPREM - DEFIMAN Cadre: Projet ANR DEFIMAN Laboratoire : IPREM UMR 5254 Pau Université de Pau et des Pays de l'Adour (UPPA) - CNRS Aquitaine et IPSIM Montpellier Durée: 12 mois - Début: Mai 2023 Contact: [email protected] Validité de l'offre: jusqu’au 31 mars 2023


GTS in collaboration with IPREM UMR5254, Université de Pau et des Pays de l'Adour (UPPA) have performed a successful experiment at MIRAS beamline in Sincrotró ALBA💡.


Participation des chercheurs de IPREM UMR5254 à la première édition du "Campus des enfants" de Université de Pau et des Pays de l'Adour (UPPA) lundi 3 et mardi 4 juillet 2023 sur le campus de Pau








